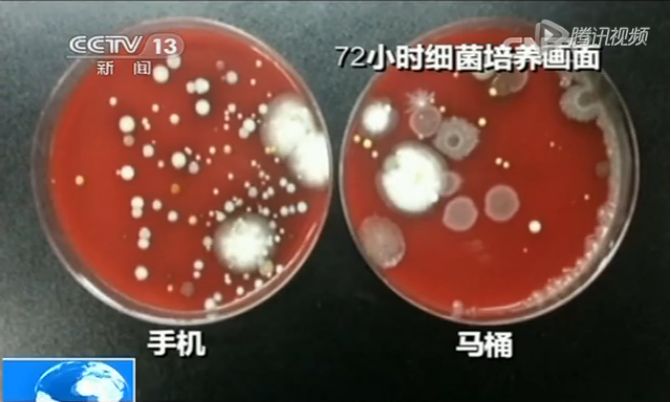
日本冠状病毒飞沫实验,日本病毒传染家庭实验

病毒更喜欢粗糙的表面,还是光滑的表面?
日本MBS电视台一档科普节目里,以大家常接触的毛巾和手机为例提出了这样一个问题。

答案是,手机(光滑)。
本期,《生命时报》提醒你注意手机这个“隐形”卫生死角,教你如何给手机消毒。
本文编辑丨罗榕
病毒在手机上存活24小时
日本呼吸道专家大谷义夫认为,比起毛巾等表面粗糙的物品,病毒更喜欢光滑的东西。
在毛巾上,病毒只能存活约15分钟↓

而在手机上,则能存活长达24小时↓

美国国家过敏和传染病研究所(NIAID)、美国疾病控制与预防中心(CDC)等机构也于3月10日发布新研究称:
在气溶胶中3小时后,仍可检测到活的新冠病毒;在铜表面,新冠病毒能存活多达4小时;硬纸板表面至多可存活24小时;在塑料或不锈钢表面则最多可存活2到3天。

带有病毒的飞沫沾染在手机等光滑物品的表面,通过指尖接触传染到手上。如果用玩过手机的手擦眼睛、吃东西,病菌就会趁机进入人体导致感染。
所以即便回家后洗了手,如果没有注意手机等随身物品的消毒,也有再次被病毒沾染的可能。

未消毒的手机有多脏
据统计人平均每天会点击手机屏幕2600多次,携带外出、随时触摸,手机一直是多种病菌的“大本营”。
细菌量是马桶的18倍
美国斯坦福大学的一项研究报告显示,在30款手机样品中,触屏手机的细菌和病毒量是男洗手间的18倍,因此成了病菌传播的媒介。
央视新闻“生活实验室”栏目分别制作了手机和马桶的72小时细菌培养皿,也证明了手机的细菌数量是马桶的18倍,并且,手机表面的细菌数量高达120000
个/平方厘米。
可能附着2000多种细菌
手机上的附着细菌多达2000余种,1/4的手机细菌总数超过正常值的10倍。最常见的是大肠杆菌及金黄色葡萄球菌,沙门氏菌、流感病毒等病菌也占比较大。
给手机消毒的正确姿势
第一步
将手机电源关闭,用纸巾擦除手机表面油脂。
第二步
将浓度为75%的医用酒精均匀喷在卫生棉球或软布上。
第三步
使用酒精棉从上到下同一方向擦拭手机屏幕、背面、侧面、按键缝隙、充电接口等部位。

第四步
将手机静置5分钟,等待手机表面酒精完全挥发。
第五步
单独对手机保护壳内外擦拭,等待手机和保护壳分别擦拭好后再佩戴。
注意事项
1.在消毒时注意将棉球里的酒精拧干再擦拭,避免酒精流入手机接口。
2.酒精属于易挥发品,在消毒过程中要远离明火和静电。
3.84消毒液对金属具有腐蚀性,不适用于手机消毒。
4.疫情期间,在公共场合尽量避免使用手机。回家后先洗手,再给手机消毒,消毒后也要记得洗手。▲
版权声明:本文为《生命时报》原创,未经授权谢绝转载。欢迎转发朋友圈。